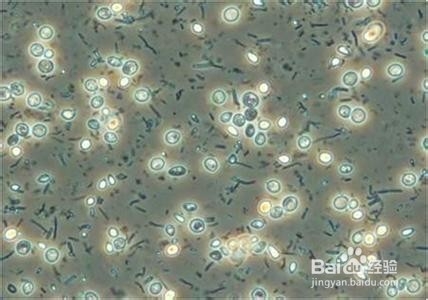
生活垃圾除臭的方法

1、植物液气相反应法:
垃圾除臭剂有效去除垃圾废气臭味及抑制臭味产生,作用持续时间长,使有机废物快速的自然分解,结合恶臭分子中和相刹的原理,快速分解去除垃圾臭味的同时抑制各种异味生成,如:硫化氢、硫醇、挥发性脂肪酸和氨气等。
特点:专业性强,快速高效,性价比高,安全环保,无毒无刺激,无二次污染。

2、微生物法
原理:利用微生物将有机物质的降解为自身所需营养物质的能力
适用对象:恶臭有机物
特点:对固、液物中恶臭溢出可起到抑制作用,但对已散发的恶臭难以发挥作用,占地广,投入高,运行管理麻烦
3、吸附法
原理:利用多孔介质对恶臭分子进行吸附
适用对象:碳氢化合物,H2s,碱酸性恶臭分子
特点:设备简单,除臭效果好,适用于低浓度恶臭气体的处理,一般用于复合恶臭的末级净化,当气体浓度高时需对气体进行水洗、酸洗、碱洗等预处理,含尘量大的气体还需先进行除尘处理,会造成二次污染

4、燃烧法
原理:恶臭物质多为可燃成分 ,燃烧后分解为无害的水和二氧化碳等无机物质
适用对象:可燃性恶臭成份
原理:在气液两相共存的体系中蒸汽态物质由于凝结变为液态物质,液态物质由蒸发变为气态物质
缺点:高成本,高耗能,且会将硫化氢氧化成二氧化硫,造成二次污染。

5、等离子法
原理:等离子体法,靠分子激发器,使用高频、高压,采用分子共振的原理
适用对象:易被分解的恶臭成份,分子结构不稳定的恶臭气体。
6、气味掩盖法:
遮蔽,用别的强烈气体覆盖恶臭,但无法去除恶臭成分。